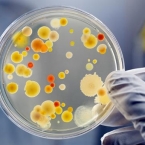

Олланд «воскресил» идею закона о криминализации отрицания Геноцида армян
28 января, в ходе организованного Координационным советом армянских организаций Франции ужина французский президент Франсуа Олланд «воскресил» идею принятия закона о криминализации отрицания Геноцида армян.